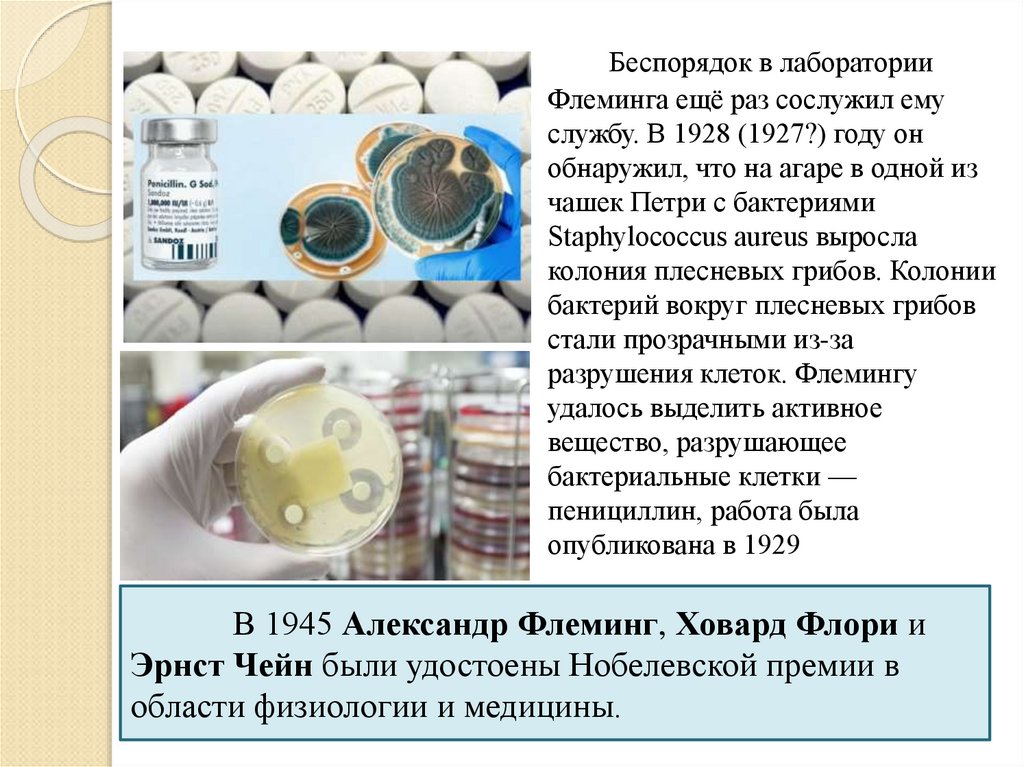

Similar presentations:
Грибы. Строение, жизнедеятельность разнообразие, роль в природе и значение в жизни человека. Микология
1. Грибы. Строение, жизнедеятельность разнообразие, роль в природе и значение в жизни человека. Микология.
2. Сходство с животными
Гетеротрофы (сапрофиты ипаразиты)
В качестве запасных питательных
веществ в клетках грибов
накапливается гликоген
В клеточной оболочке содержатся
полисахариды (хитин)
3. Сходство с растениями
Малая подвижность ввегетативном состоянии
Неограниченный рост
Размножение спорами
Поглощение веществ путем
всасывания
4. Общие признаки грибов
Гетеротрофное питаниеЗапасное питательное вещество
гликоген
Поглощение питательных веществ
путем всасывания
Наличие клеточной стенки из хитина
Неограниченный рост
Тело – грибница (мицелий)
5.
Тело гриба – грибница (мицелий)состоит из тончайших нитей – гиф
Гифы высших грибов разделены на
отдельные клетки с одним или
несколькими ядрами
У шляпочных грибов образуются
плодовые тела, состоящие из пенька и
шляпки
Плодовое тело образовано плотно
прилегающими гифами мицелия
6.
Шляпочные грибыТрубчатые
Пластинчатые
7.
8.
9. Съедобные или ядовитые?
ГрибыЯдовитые Съедобные
10.
11. Отличия бледной поганки от шампиньона
Бледная поганка под шляпкой имеетпластины белого цвета, а у молодых
шампиньонов пластины розовые, у
старых – коричневые.
У бледной поганки при повреждении цвет
мякоти не изменяется, а у шампиньона
мякоть становится красной или жёлтой.
12.
Запах шампиньона напоминает запаханиса или миндаля, у молодых поганок
запах отсутствует вообще.
Возле шампиньонов можно обнаружить
мух или червей, в то время, как поганки
редко бывают для них
привлекательными.
Подробнее: http://thedifference.ru/kakotlichit-blednuyu-poganku-otshampinona/
13. Ядовитые грибы
1)2)
Отравление грибами и степень
его тяжести зависят от того:
какие ядовитые вещества
содержит тот вид грибов, что
был употреблен в пищу;
в каком количестве поступил яд
в организм человека.
Отравление грибами тем
опаснее, чем длиннее
промежуток между едой и
проявлением первых симптомов
отравления.
14.
Размножение грибовПоловое
Бесполое
Вегетативное
Частями
мицелия
Почкованием
С помощью спор
Образование
специализированных
половых клеток –
гамет и их слияние
Слияние
содержимого двух
клеток на концах
гиф
15. В жизненном цикле грибов происходит смена гаплоидной и диплоидной фаз
Грибы – гаплобионтыКлетки вегетативного тела гаплоидны,
диплоидна только зигота
Грибы – диплобионты
На протяжении всей жизни диплоидны,
гаплоидны только гаметы
16. Разнообразие грибов
17.
18.
19.
20. Разнообразие грибов
21. Разнообразие грибов Хищный гриб
22. Плесневые грибы
23. Плесневый гриб мукор
24.
25. Плесневый гриб пеницилл
26.
Низший грибМукор
Высший гриб
Пеницилл
27.
28. Одноклеточные грибы. Дрожжи
29.
Классификация царства грибовоснована прежде всего на
способе размножения
Хитридиомицеты
Зигомицеты
Аскомицеты (Ascomycota)
или Сумчатые грибы
Базидиомицеты
Дейтеромицеты (Несовершенные грибы)
30.
Царство ГрибыНизшие
(Около 10%)
Хитридиомицеты
Микроскопические и
одноклеточные формы,
образующие
цитоплазматическую
массу
Паразиты водорослей,
водных грибов и
высших растений,
беспозвоночных
животных
Зигомицеты
Одноклеточные
Большинство
видов паразиты
или хищники
микроскопических
животных (амёбы,
нематоды, личинки
насекомых), паразиты
грибов
Мукор
Аскомицеты
Сумчатые грибы
Многоклеточные , их
споры, содержатся в
специальных сумках
Разлагают органику,
встречаются
паразиты
Высшие
(Около 90%)
Базидиомицеты
Дейтеромицеты
Несовершенные
грибы
Мицелий
многоклеточный,
органы
спороношения базидии
Мицелий состоит
из многоядерных
клеток, бесполое
размножение
Разлагают органику.
Часть тела может
находиться на
поверхности, часть
погружена в почву
Разлагают
органику,
встречаются
паразиты
Дрожжи
Ольпидиум
Шляпочные
грибы
Триходерма
Синхитриум
Зоопаговые
Трутовики
Сморчки
Боверия
31.
Классификация грибовКласс (Отдел)
Особенности
строения
Особенности
жизнедеятельности
Представители
Хитридиомицеты
Микроскопические и
одноклеточные формы,
образующие
цитоплазматическую
массу
Паразиты водорослей,
водных грибов и
растений,
беспозвоночных
животных
Ольпидиум (черная
ножка капусты),
синхитриум (рак
картофеля)
Зигомицеты
Одноклеточные
Наземные, разлагающие
органику, встречаются
паразиты
Мукор
Аскомицеты
Многоклеточные
формы споры, которых
содержатся в
специальных сумках
Разлагают органику,
встречаются паразиты
Дрожжи, спорынья,
сморчки, строчки,
трюфель
Мицелий
многоклеточный,
органы спороношения базидии
Разлагают органику.
Часть тела может
находиться на
поверхности, часть
погружена в почву
Шляпочные грибы,
трутовики
Мицелий состоит из
многоядерных клеток,
бесполое размножение
Разлагают органику,
встречаются паразиты
Боверия,
триходерма
более 32000 видов (~30 %
всех известных науке
видов грибов).
Базидиомицеты (около
30000 видов) большинство
грибов, употребляемых
человеком в пищу, а также
ядовитых грибов и паразитов
культурных и диких растений
Дейтеромицеты
(несовершенные грибы).
Насчитывают около 30 000
видов
32. Грибы подразделяют на низшие и высшие
НИЗШИЕ ГРИБЫВЫСШИЕ ГРИБЫ
Организмы без мицелия,
или имеющие
неразделенный мицелий
(мукор, фитофтора,
возбудитель рака
картофеля)
Организмы с хорошо
развитым
разделенным
мицелием
(исключение
дрожжи)
Хитридиомицеты
Зигомицеты
Аскомицеты,
Базидиомицеты и
Дейтеромицеты
объединяют в
группу Высшие
грибы (Dikarya).
33. Значение грибов в природе
Способствуют повышениюплодородия почвы (редуценты)
Вступают в симбиотические связи с
другими организмами (микориза,
или грибокорень; тело лишайников)
Являются пищей животных
Вызывают болезни растений и
животных
34. Микориза
35.
36. Значение в жизни человека
ПищаАнтибиотики, органические кислоты, ферменты,
витамины
Хлебопечение
Производство спирта
Виноделие
Производство кормовых белков
Производство биопрепаратов для защиты растений от
вредителей и болезней
37. Значение в жизни человека
Производство по выращиванию шампиньоновГрибная ферма. Выращивание вешенки
38. Значение грибов в жизни человека
39. История получения антибиотиков
Александр Флеминг (1881 – 1955) - британский бактериолог.Открыл лизоцим (антибактериальный фермент, вырабатываемый
человеческим организмом) и впервые выделил пенициллин из
плесневых грибов Penicillium notatum — исторически первый антибиотик
40.
Беспорядок в лабораторииФлеминга ещё раз сослужил ему
службу. В 1928 (1927?) году он
обнаружил, что на агаре в одной из
чашек Петри с бактериями
Staphylococcus aureus выросла
колония плесневых грибов. Колонии
бактерий вокруг плесневых грибов
стали прозрачными из-за
разрушения клеток. Флемингу
удалось выделить активное
вещество, разрушающее
бактериальные клетки —
пенициллин, работа была
опубликована в 1929
В 1945 Александр Флеминг, Ховард Флори и
Эрнст Чейн были удостоены Нобелевской премии в
области физиологии и медицины.
41. Значение грибов в жизни человека. Получение органических кислот, ферментов и витаминов.
42. Значение грибов в жизни человека
ХлебопечениеПроизводство спирта
Виноделие
Производство кормовых белков
43. Производство биопрепаратов для защиты растений от вредителей и болезней.
44. Отрицательная роль грибов
Болезнисельскохозяйственных
растений
Болезни животных и
человека - МИКОЗЫ
45. Болезни растений, вызываемые грибами
Раккартофеля
Фитофтора
картофеля
46.
Ржавчинныегрибы
Мучнистая
роса
Черная ножка
Грибы-трутовики на древесных растениях
47.
В Средние века в год,когда из-за погодных
условий развитие
спорыньи усиливалось, изза употребления хлеба из
зерна, поражённого
спорыньёй, возникали
эпидемии так называемого
«Антониева огня»
(эрготизма) — пищевого
токсикоза алкалоидами
спорыньи.
48.
Склероций спорыньисодержит большое
количество алкалоидов,
наиболее ядовитый из
которых — эрготинин, при
употреблении в пищу
вызывающий судороги и
длительные спазмы гладкой
мускулатуры; также при
отравлении наблюдаются
расстройства психики,
нарушение
глазодвигательной функции,
а спустя несколько месяцев
— осложнённая катаракта,
большие дозы приводят
человека к гибели
49.
Головня назлаковых
Склероции
спорыньи в
колосьях злаковых
В настоящее время
методы агротехники
позволили практически
избавиться от спорыньи в
сельскохозяйственных
посевах.

biology
biology








